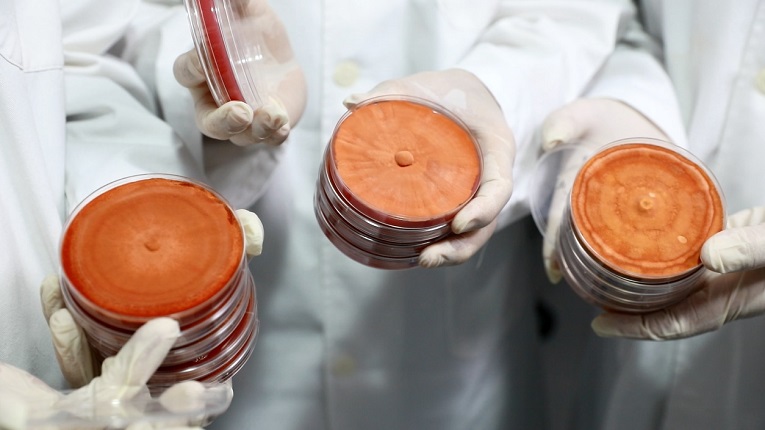
甘泉生技以特有專利技術：菌種異地動態保存系統(Strain Dynamic Offsite Storage system, S-DOS系統)從原料生產加入B2B2C鏈結的多元合作。圖／甘泉生技提供

宇洋聯手甘泉、傑安,B2B2C策略聯盟整合開發 《工商時報》
2021.10.29

宇洋生醫後疫情時代專屬保健新品整合開發。圖左起為傑安生技總經理蔣文欽博士、甘泉生技總經理張閎積、宇洋生醫行銷總監黃建誠、丘錦朋博士。圖/宇洋生醫提供
宇洋生醫深耕食品發酵已經超過20年,產品研發包括保健食品、口腔清潔、美妝保養、外用洗劑等項目,生產製程除了具有ISO22000與HACCP國際認證,也通過清真認證。

宇洋生醫跨界應用果蔬發酵核心技術,進行酸奶(優格)生技飲品、保健產品的B2B2C策略聯盟整合。圖/宇洋生醫提供
自2017年起成立新創事業部,針對台灣特有的手搖飲料店市場,將果蔬發酵核心技術跨界應用,開發酸奶(優格)生技飲品,首創「酸奶手搖飲」品牌:優握握-酸奶大獅。2021年起,因應新冠肺炎後疫情時代的市場快速變化、消費方式改變,宇洋快速反應、積極以「資源整合打群架」的「策略聯盟」方式進行B2B2C的公司間合作,藉由既有技術、行銷、通路的資源互換,降低成本、創造多贏。
甘泉生技以特有專利技術:菌種異地動態保存系統(Strain Dynamic Offsite Storage system, S-DOS系統)從原料生產加入B2B2C鏈結的多元合作。圖/甘泉生技提供
甘泉生技為牛樟芝子實體原料生產的老品牌,2008年第一家首創皿培式培養,活性成分完美複製野生牛樟芝,建立特有專利核心技術:菌種異地動態保存系統(Strain Dynamic Offsite Storage system, S-DOS系統),更具領先業界的培養基自動化生產製程、牛樟芝8大活性指標成分的高效液相層析(HPLC)監測、提取純化技術。在此市場多變的後疫情時代,公司角色從原料生產加入B2B2C鏈結的多元合作。

傑安生技以製藥等級的高規格科學驗證進行後疫情時代專屬保健產品研發。圖/傑安生技提供
傑安生技由美國必治妥製藥大廠(BMS)藥物研發首席專家蔣文欽博士於2015年創立,聚焦標靶抗癌新藥、抗衰老保健食品、三高循環保健食品、高端皮膚保養品的開發,依循最嚴謹的製藥觀點與規格,經科學驗證確認產品對適應症的有效性,更以活性成分作為控管基準,確保品質與功效的一致性。在B2B2C鏈結合作中,針對疫情流感化、病毒快速變異,投入後疫情時代專屬健康保健產品的研發。
如何在後疫情時代提升自我保護力與新冠病毒長期抗戰,為民眾日常飲食、防疫保養的重要課題之一,宇洋聯手甘泉、傑安,依據最新「腸肺軸」(Gut-lung axis)科學進行酸奶手搖飲深度研究,更結合牛樟芝、綠茶兒茶素、薑黃等素材開發複方花茶、全素膠囊保健品,以資源共享的策略聯盟方式逐步建立O2O (Online To Offline)線上線下整合營銷,希望在此健康、經濟最變動的時期,給予消費者CP值性價比最高的服務與產品。